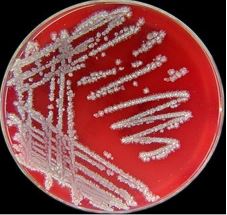
Thống kê các chủng vi sinh vật xử lý nước thải và chức năng của chúng Thống kê các chủng vi sinh vật xử lý nước thải và chức năng của chúng

Xử lý nước thải bằng phương pháp sinh học là một công nghệ xử lý hiệu quả, do tính hiệu quả về mặt chi phí và khả năng tương thích với môi trường, phương pháp xử lý sinh học sử dụng vi sinh vật đã và đang được áp dụng trong hầu hết các hệ thống xử lý nước thải hiện nay. Vậy các chủng vi sinh vật thường có trong hệ thống xử lý nước là những chủng vi sinh vật nào và chức năng của chúng ra sao?

Thống kê các chủng vi sinh vật xử lý nước thải phổ biến
– Chủng vi sinh vật Bacillus
Nói đến chủng vi khuẩn xử lý nước thì không thể không nhắc đến chủng vi khuẩn Bacillus, phổ biến với 3 nhóm sau:
- Bacillus subtilis (viết tắt: B. subtilis): Là tên khoa học của “trực khuẩn suptilit”. Đây là một loài vi khuẩn gram dương và có hình que, hiếu khí không bắt buộc.
- Bacillus licheniformis (viết tắt: B. lichenformis): Là một vi khuẩn gram dương và thường được tìm thấy trong đất. Khi ở trong điều kiện môi trường không thuận lợi, chủng vi khuẩn Bacillus licheniformis có thể tồn tại ở dạng bào tử không hoạt động và khi có điều kiện tốt, chúng ở trạng thái sinh dưỡng.
- Bacillus amyloliquefaciens (viết tắt: B. amyloliquefaciens): Tưởng tự như vi khuẩn B. subtilis và B. lichenformis Cũng là một vi khuẩn đất gram dương, các tế bào thường xuất hiện thành chuỗi dài không giống như nhiều loài Bacillus khác mà hình thành các tế bào đơn lẻ. Tương tự như các loài Bacillus khác, Bacillus amyloliquefaciens hình thành nội bào tử, cho phép chúng tồn tại trong một thời gian dài.
![]() |
![]() |
![]() |
| Bacillus subtilis | Bacillus licheniformis | Bacillus amyloliquefaciens |
– Chủng vi sinh vật Clostridium
Clostridium thuộc ngành Firmicutes và là một giống trực khuẩn Gram dương. Đây là một trong những vi khuẩn kỵ khí bắt buộc và có khả năng sinh nha bào khi môi trường sống bất lợi. Chủng Clostridium trong xử lý nước thải thường 2 loại vi sinh có độ hoạt tính cao, cụ thể là Clostridium butyricum và Clostridium sartagoforme.
- Clostridium butyricum: Clostridium butyricum là một loại trực khuẩn gram dương hình thành nội bào tử kỵ khí bắt buộc, sản xuất trực khuẩn tồn tại bằng phương pháp lên men sử dụng α-polyglucan giống amylopectin tích lũy nội bào làm chất nền.
- Clostridium sartagoforme: Một loại vi khuẩn kỵ khí gram dương, có thể tạo ra bào tử.
– Chủng vi sinh vật Desulfovibrio
Desulfovibrio là một chi vi khuẩn Gram âm khử sulfat ưa ấm. Các loài Desulfovibrio thường được tìm thấy trong môi trường nước có hàm lượng chất hữu cơ cao, cũng như trong môi trường đất ngập úng.
– Chủng vi sinh vật Pseudomonas
Pseudomonas là một chi vi khuẩn xuất hiện ở mọi nơi trong môi trường. Đặc điểm hình thái học chung cho Pseudomonas là Gram âm, tế bào hình que, di động nhờ roi ở đầu và không có bào tử. Là vi khuẩn dị dưỡng, không lên men, linh hoạt về dinh dưỡng, không quang hợp hoặc cố định Nitrogen.
– Chủng vi sinh vật Rhodopseudomonas Palustris
Rhodopseudomonas Palustris (viết tắt R. Palustris) – vi khuẩn tía (gọi đầy đủ là vi khuẩn tía quang hợp). Đây là nhóm vi khuẩn có khả năng trao đổi chất rất linh hoạt, có thể sử dụng đa dạng những hợp chất hữu cơ để làm nguồn Cacbon hay dùng Sulfide để làm chất cho điện tử trong quang hợp.
– Chủng vi sinh vật Nitrosomonas
Là một chi vi khuẩn gram âm, thuộc nhóm Betaproteobacteria. Nó là một trong năm chi vi khuẩn oxy hóa Amoniac, với tư cách là một chất hóa học tự dưỡng bắt buộc, sử dụng Amoniac (NH3) làm nguồn năng lượng và Carbon Dioxide (CO2) dưới dạng nguồn Carbon khi có mặt oxy.

– Chủng vi sinh vật Nitrobacter
Nitrobacter là một chi bao gồm các vi khuẩn hình que, gram âm và hóa dưỡng. Chúng không chuyển động và sinh sản thông qua nảy chồi hoặc phân đôi.Các tế bào Nitrobacter là các sinh vật hiếu khí bắt buộc và có thời gian tăng gấp đôi trong khoảng 13 giờ.

Sản phẩm Microbe-Lift chứa các chủng vi sinh vật xử lý nước thải hoạt tính mạnh
Vi sinh xử lý nước thải MICROBE-LIFT là sản phẩm cốt lõi của dòng sản phẩm vi sinh môi trường. Chứa quần thể vi sinh được nuôi cấy dạng lỏng hoạt động mạnh gấp 5 đến 10 lần vi sinh thông thường bao gồm những chủng vi khuẩn như: Bacillus amyloliquefaciens, Bacillus licheniformis, Bacillus subtilis, Clostridium butyricum, Clostridium sartagoforme, Desulfovibrio vulgaris, Desulfovibrio aminophilus, Methanomethylovorans hollandica, Methanosarcina barkeri, Pseudomonas citronellolis, Rhodopseudomonas palustris, Nitrosomonas, Nitrobacter,…

Chức năng chính của những chủng vi sinh vật có trong vi sinh Microbe-Lift
- Bacillus subtilis: Giúp loại bỏ Ammonia Nitrogen, giảm Protein và làm suy thoái Hydrocarbon, suy thoái Amin. Bên cạnh đó, Bacillus subtilis còn giúp thủy phân tinh bột và các sản phẩm chứa tinh bột thành đường Glucose.
- Bacillus licheniformis: Có chức năng loại bỏ Ammonia Nitrogen và giảm Protein.
- Bacillus amyloliquefaciens: Giúp loại bỏ ammonia nitrogen, suy thoái amin, giảm protein.
- Clostridium butyricum: Công dụng ức chế E.Coli, giảm hàm lượng lớn chất hữu cơ phức tạp.
- Clostridium sartagoforme: Giúp loại bỏ nitơ hữu cơ; giảm chất hữu cơ phức tạp.
- Desulfovibrio vulgaris: Giảm lưu huỳnh, loại bỏ kim loại nặng.
- Methanomethylovorans hollandica: Giảm lưu huỳnh, kiểm soát mùi.
- Pseudomonas citronellolis: Loại bỏ amoniac; hấp thụ phốtpho, giảm chất hữu cơ phức tạp, Pseudomonas còn tham gia vào quá trình chuyển hóa nitrat (NO3-) thành Nitơ phân tử (N2) bay vào không khí.
- Rhodopseudomonas palustris: Giảm Photpho, kiểm soát mùi, giảm hợp chất Hydrocacbon.
- Nitrosomonas: Công dụng chuyển hóa Amoniac (NH3, NH4 – dạng chính của Nitơ khi tồn tại trong nước) thành Nitrit (NO2).
- Nitrobacter: Công dụng chuyển hóa Nitrit thành Nitrat (NO3), kết thúc quá trình Nitrat hóa.
Ưu điểm khi sử dụng các chủng vi sinh xử lý nước thải được bảo quản dạng lỏng
Khi sử dụng chủng vi sinh xử lý nước thải được bảo quản ở dạng lỏng, chúng sẽ mang đến nhiều thuận lợi cho quá trình vận hành hệ thống xử lý nước thải, điển hình như:
- Khả năng sống của các chủng vi sinh vật và thời gian kích hoạt nhanh hơn nhiều so với men vi sinh dạng bột, cụ thể là không cần thời gian ngâm ủ, vì các chủng vi sinh đang được ức chế ở logarit của giai đoạn phát triển của vi sinh, vì vậy vi sinh sẽ “tỉnh dậy” hoạt động ngay sau quá trình “ngủ đông” khi sản phẩm được mở ra và đưa vào xử lý, không cần tốn thời gian ngâm, kích hoạt trước đó.
- Vi sinh dạng lỏng ít tốn chi phí hơn do liều dùng duy trì thấp khi sử dụng thời gian lâu dài: Vi sinh dạng lỏng chứa các chủng vi sinh có hoạt tính mạnh, khả năng sống cao và hiệu quả xử lý chất ô nhiễm tốt, nên khi bổ sung vào hệ thống khả năng thích nghi cao hơn do đó liều lượng dùng để duy trì vận hành hệ thống đạt chuẩn đầu ra là khá thấp, giúp tối ưu hơn chi phí vận hành cho nhà máy.

Với những chia sẻ nêu trên mong rằng có thể giúp bạn hiểu rõ hơn về chủng vi sinh vật trong chế phẩm sinh học xử lý nước thải. Để được tư vấn chi tiết hơn về các phương pháp xử lý nước thải bằng công nghệ sinh học, xin hãy liên hệ ngay với BIOGENCY theo HOTLINE 0909 538 514.
>>> Xem thêm: Ảnh hưởng của độ mặn đến vi sinh vật trong quá trình bùn hoạt tính